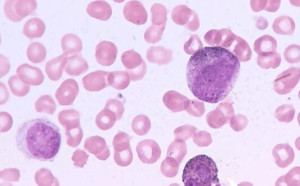

- 新聞動態(tài)News center
- 【推薦】大家都在看
- 聯(lián)系我們Contact us
-
- 環(huán)檢檢測
- 熱線:400-000-1279
- 手機:13819451621(微信同號)
- 地址:杭州市蕭山區(qū)新塘科創(chuàng)園3-418室
室內(nèi)環(huán)保資訊
別讓孩子活在“甲醛之殤”的悲劇中
時間:2019-07-16 作者:環(huán)檢檢測

白血病是近年來各種兒童癌癥中發(fā)病率最高的一種,兒童癌癥中有30-40%是白血病。根據(jù)《中國癌癥登記年報》統(tǒng)計,我國0-14歲兒童白血病發(fā)病率為3.44/10萬。照此計算,每年我國新增0-14歲兒童白血病患者約8000人。就在去年,曾出演過央視蛇年春晚的“福娃娃”“年畫娃娃”鄧鳴賀也因白血病復(fù)發(fā)去世。越來越幼小的生命因白血病失去。人們除了唏噓的同時也不免疑惑,為什么現(xiàn)在罹患白血病的兒童這么多呢?

隨著經(jīng)濟和人們生活水平的不斷提高,國內(nèi)一度發(fā)生了裝修熱潮,而裝修污染正是兒童白血病的罪魁禍首。經(jīng)調(diào)查發(fā)現(xiàn),90%的兒童白血病患者半年內(nèi)家中都裝修過。醫(yī)學(xué)研究證明,室內(nèi)甲醛污染已經(jīng)成為兒童白血病高發(fā)的主要原因。一些廠商為了追求利益大量生產(chǎn)廉價的裝修材料。劣質(zhì)的人造板材、家具、裝飾物殘留的或分解出來的甲醛會逐漸向周圍環(huán)境中釋放,最長釋放期可達十幾年。甲醛猶如一個隱形殺手潛伏在我們的家中,時時刻刻的在侵蝕著我們的健康。但甲醛的危害較為隱性,難以為肉眼所察覺,故而人們?nèi)菀缀鲆暎覀兗彝コ蓡T中最脆弱的兒童、孕婦和老人對甲醛尤為敏感,甲醛對他們的危害也更大。因為對甲醛的認知貧瘠、沒有科學(xué)的教育,社會忽視等問題的影響下,“甲醛之殤”的悲劇才會一次次的上演,無數(shù)個失去孩子的家庭正為此承受著巨大的悲痛。
為了喚起人們?nèi)嫔羁痰卣J識甲醛到危害,2015年4月26日,由中國林業(yè)產(chǎn)業(yè)聯(lián)合會、工業(yè)協(xié)會聯(lián)合環(huán)保家居品牌好萊客、紅星美凱龍等機構(gòu)、知名人士、媒體共同發(fā)起和倡導(dǎo),在中國上海舉辦了第一屆世界無醛日的啟動儀式;并將往后每年的4月26日定為世界無醛日。世界無醛的日的成立,不僅有助于人們了解生活中甲醛的來源、危害以及防患等,也希望引發(fā)社會各界的關(guān)注,讓更多的兒童白血病患者能夠得到更多的關(guān)懷,找到重獲新生的希望。

別再讓甲醛之殤的悲劇重演,世界無醛日,讓我們一起用行動拒絕甲醛危害。共同攜手為家人、后一代創(chuàng)建為一個安全的生活環(huán)境刻不容緩!
推薦閱讀:上海甲醛檢測丨
關(guān)于環(huán)檢

環(huán)檢CMA檢測實驗室擁有專業(yè)的技術(shù)團隊,配備各類先進的檢測儀器,可以滿足絕大部分污染檢測需求。杭州環(huán)檢檢測科技有限公司是一家專業(yè)從事第三方檢驗檢測技術(shù)服務(wù)的高新技術(shù)企業(yè),業(yè)務(wù)范圍輻射整個中國。本中心主要檢測服務(wù)項目為專業(yè)的室內(nèi)污染檢測及人造材料污染物釋放量和含量檢測,涵蓋甲醛檢測、氨氣檢測、氡氣檢測、TVOC檢測、苯系物檢測等等。
相關(guān)資訊
- 2019-11-14做室內(nèi)除甲醛市場大前景怎么樣嗎?
- 2019-11-13室內(nèi)甲醛超標怎么去除
- 2019-11-12一般室內(nèi)除甲醛都是使用什么技術(shù)?
- 2019-11-11鹽城室內(nèi)甲醛檢測多少錢一次?
- 2019-11-11室內(nèi)放水除甲醛是誤區(qū)還是土辦法
- 2019-11-11室內(nèi)除甲醛用醋可以嗎
- 2019-11-11室內(nèi)空氣治理有沒有效果?
- 2019-11-11室內(nèi)快速除甲醛的方法有哪些
- 2019-11-08室內(nèi)加溫可以去除甲醛嗎?
- 2019-11-08室內(nèi)甲醛安全范圍是多少?
- 2019-11-08室內(nèi)通風多久才能除甲醛?
- 2019-11-08室內(nèi)除甲醛有用嗎?



